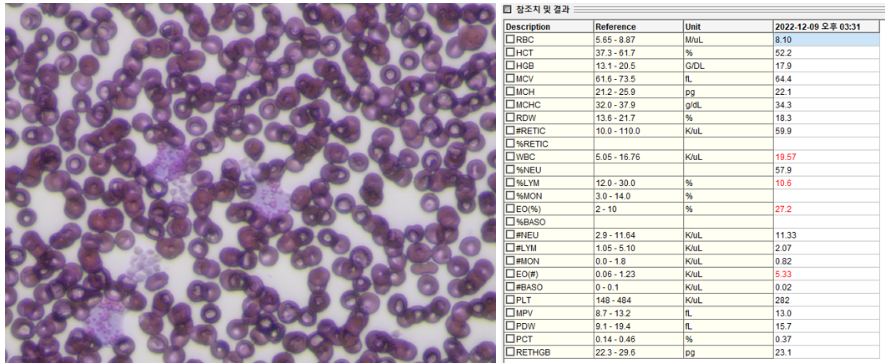
20251208_145527.png

VIP동물의료센터는
심도 있는 치료까지 책임집니다.
강아지 호산구성 폐렴의 임상적 특징과 치료 반응 증례 소개
- 작성자
- 관리자
- 등록일
- 2025-12-08
- 조회수
- 41
강아지 호산구성 폐렴의 임상적 특징과 치료 반응 증례 소개
■ 환자 기본 정보
동물 이름 : 쫑이(가명)
나이 : 8살
성별 : 중남
품종 : 폼피츠

■ 내원 당시 환자의 상태
8살령의 폼피츠 똘이는 지역병원에서 기침증상으로 항생제 등을 복용하였으나
날로 심해져가는 임상증상과 방사선 상 폐침윤 증상 심화로 본원에 내원하였습니다.
내원 당시 청색증을 보이고 청진 상 crackle 명확하게 들렸으며, 심잡음은 청진되지 않았습니다.
흉부방사선 상에서 폐전엽에 걸친 침윤이 있었으며 복배상에서는 결절로 의심되는 부분도 확인되었습니다. ▼

■ 검사 방법 및 결과
환자의 중증도를 파악하기 위해 혈액검사와 전염병 감별을 위해 추가 검사를 진행하였습니다.
홍역, 인플루엔자, 심장사상충 검사에서 전부 음성이 나왔으며 혈청화학검사와 혈액가스에서
특이사항 없었으며 염증수치조차 정상으로 확인되었습니다.
특이점으로는 CBC검사 결과에서 백혈구 증가증이 있었으며 그 중 호산구의 증가 비율이 비정상적으로 높았습니다.
실제로 호산구가 말초혈액 내에서 증가했는지 확인해보기 위해 혈액도말 검사를 진행하였으며
실제로 호산구가 백혈구 중 압도적으로 많은 것을 확인하였습니다.
이전 지역병원에서 처방한 항생제에 대한 반응이 아예 없었다는 것과 호산구의 증가와 폐엽 내 결절의심소견이 확인된 것으로 추가 검사를 진행하였습니다.
그 검사로는 CT검사와 Bronchoalveolar lavage(폐세척 검사)를 통해 종양과 폐렴, 폐렴 중에서는 세균성, 곰팡이성, 호산구성 폐렴 감별해야 했습니다. ▼
CT검사 상에서 폐엽 전체에 걸친 침윤을 확인하였으며 일부엽에서는 조영증강을 동반한 결절도 확인되었습니다.
해당 결절은 종양가능성 혹은 심한 염증으로 인한 육아직 형성 등으로 생각이 되었어서 예정대로 폐세척 검사(BAL)도 진행하였습니다. ▼

■ 수술 / 치료 및 경과
폐세척 검사를 진행하였으며 세척액 일부는 항생제 감수성와 호흡기 PCR검사를 보냈으며
나머지는 원심분리하여 현미경 검사를 진행하였습니다. ▼
결론적으로 폐세척액 검사에서 PCR과 배양검사는 모두 음성이 나왔으며 현미경 검사 상
다량의 호산구와 중등도의 호중구가 발견되었으며 이분화된 핵을 가진 세포들이 다수 발견되어
정밀적인 검사를 위해 세포학 검사도 의뢰하였습니다.
세포학 검사에서는 호산구성 폐렴과 호중구성 폐렴으로 진단되었으며 폐결절에 대해서는
폐엽절제를 통한 조직검사가 추천되었으나 염증으로 인한 육아직일 수 있고 환자 호흡이 너무 좋지 않았으며
보호자님도 일단 스테로이드를 통한 치료를 먼저 원하셔서 PDS 1mg/kg/day와 항생제 치료를 시작하였습니다.

스테로이드와 항생제 그리고 수액처치 후 환자의 개선속도는 급격하게 좋아졌으며
기침 호흡곤란 증상도 매우 좋아졌습니다. (방사선은 치료 후 3일 경과 사진) ▼

현재도 지속적으로 스테로이드 치료를 하고 있으며 용량을 천천히 감량하면서 지켜보고 있습니다.
스테로이드 치료를 함에 따라 혈 중 호산구 수치도 눈에 띄게 낮아지는 것도 함께 확인되었습니다.
기타 염증과 관련된 수치는 지속적으로 정상인 수치를 보였습니다. ▼

호산구성 폐렴(Eosinophilic Pneumonia)은 크게 확정형과 비확정형으로 구분되며,
확정형의 경우 기생충이나 곰팡이 같은 감염성 요인, 혹은 약물‧독성 물질 등이 원인이 되어 발생합니다.
반면 비확정형 호산구성 폐렴은 과호산구성 증후군에 의해 전신적으로 나타나는 경우와
특별한 원인이 밝혀지지 않는 고립형 호산구성 폐렴으로 나누어지며,
실제 임상에서는 강아지에게서 비확정형 형태가 더 흔하게 확인됩니다.
이러한 이유로 정확한 평가와 체계적인 진단이 매우 중요한데,
특히 원인이 명확하지 않은 경우에는 영상검사와 혈액학적 분석, 기도세척검사 등을 통해 종합적인 판단이 필요합니다.
호흡기 증상은 초기에 가벼워 보여도 빠르게 악화될 수 있으므로,
보호자님께서는 이상 징후가 발견될 경우 가능한 한 빨리 동병원에 내원해 정확한 검사를 받으시길 권장드립니다.
VIP동물의료센터 노원점 양재형 팀장